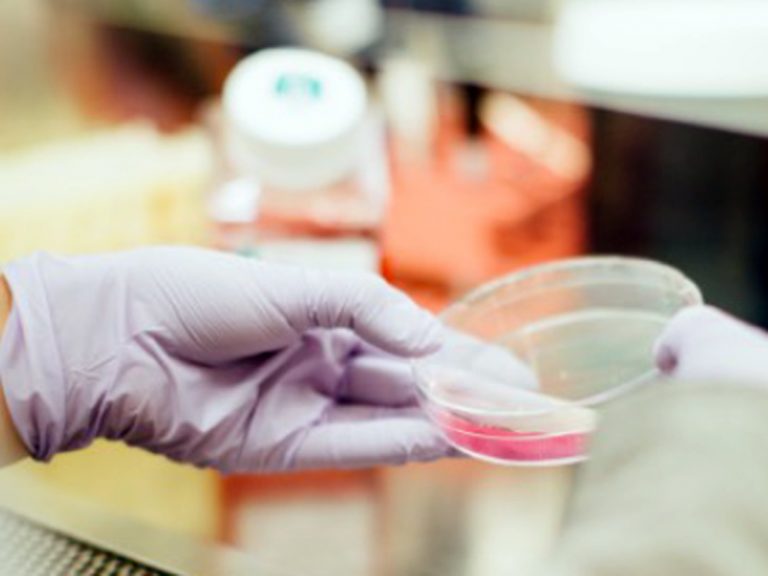

Domenica 16 febbraio, a Cesano Maderno, un nuovo appuntamento dei «Dialoghi in cripta». Ospite dell’incontro la scienziata e Senatrice a vita, Elena Cattaneo, che proporrà una riflessione su “Fede nella scienza o scienza come Fede?”
L’idea è di porre l’attenzione su alcuni quesiti che l’avanzare della conoscenza scientifica e tecnologica porta con sé:
– qual è il confine tra aver fiducia nel metodo scientifico e vivere la Scienza come fosse una nuova fede?
– come far convivere la libertà di cui ha bisogno la Scienza con quella di cui ha bisogno l’Uomo?
– cosa possiamo chiedere alla Politica, affinché la Ricerca in Italia sia un motore di vero sviluppo?
L’idea è di porre l’attenzione non tanto sul rapporto, a volte contrapposto, a volte riconciliato, tra pensiero scientifico e quello religioso, quanto invece sulla tendenza che vede la
Scienza o le sua versione più tangibile che chiamiamo Tecnologia, come fosse una nuova fede, da cui aspettarci tutte le risposte alle domande che la nostra umana condizione
ci pone. L’impressione è di essere di fronte a un Uomo che si sente straordinariamente forte. Ha dalla sua parte continue scoperte e innovazioni che lo portano a un soffio dal poter
creare la vita, dal poter decidere se salvare o distruggere il pianeta che abita, dall’autodeterminazione del proprio destino.
L’appuntamento è alle 16 presso la cripta della chiesa Santo Stefano.
L’iniziativa “Dialoghi in Cripta” è stata avviata lo scorso anno, con la collaborazione del Circolo Culturale Don Bosco, un’associazione attiva a Cesano Maderno da oltre quarant’anni. L’obiettivo dei Dialoghi è tentare di affrontare i grandi temi dei nostri tempi con l’aiuto di esperti che possano condividere la propria esperienza diretta. Il luogo in cui si tengono gli incontri, la cripta della chiesa parrocchiale, diventa metafora del tentativo di andare “sotto la superficie”, avvalendoci appunto di una guida che possa aiutarci su temi tanto difficili quanto attuali.

